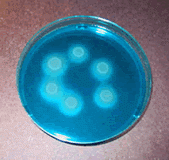

Basic Information: Pathogen Equivalency Committee
The information will help guide you through the pathogen equivalency processes.
On this page:
- Introduction
- What is the Pathogen Equivalency Committee?
- What are Processes to Further Reduce Pathogens (PFRPs) and Processes to Significantly Reduce Pathogens (PSRPs)?
- I have developed or have an idea for a new treatment process and would like to get equivalency. How do I get started?
- How can a process receive a national vs. site-specific equivalency recommendation?
- What is the difference between proof-of-concept, laboratory, pilot, and full scale?
- What are the benefits of obtaining an equivalency over operating under Alternatives 3 & 4 for Class A, or Alternative 1 for Class B?
- What are fecal coliform, Salmonella spp., enteric viruses, and helminth ova and why were they chosen to demonstrate equivalency?
Introduction
According to the 40 CFR Part 503 sewage sludge standards, before sewage sludge can be applied to land, it must meet one of six alternatives for Class A or one of three alternatives for Class B pathogen reduction levels. This can be demonstrated in three ways, as is outlined in various sections of EPA report Pathogens and Vector Attraction in Sewage Sludge:
- Treatment with an existing process or defined conditions as detailed in 40 CFR Part 503. Options consist of defined time and temperature conditions (Class A, Alternative 1), defined alkaline treatment conditions (Class A, Alternative 2)), one of 6 existing processes to further reduce pathogens (Class A, Alternative 5), or one of 5 existing process to significantly reduce pathogens (Class B, Alternative 2).
- Treatment with a process which has been granted equivalency to a process to further reduce pathogens (Class A, Alternative 6) or a process to significantly reduce pathogens (Class B, Alternative 3).
- Exhaustive microbial testing during each monitoring event (Class A, Alternatives 3 & 4, or Class B, Alternative 1.
Innovative sewage sludge processes can gain regulatory acceptance through Class A, Alternative 6 or Class B, Alternative 3. The process by which such equivalencies can be obtained is typically managed by the Pathogen Equivalency Committee and overseen by the permitting authority.
What is the Pathogen Equivalency Committee?
- A federally sponsored technical group
- Provides technical assistance
- Gives recommendations on process equivalencies for pathogen reduction in sewage sludge to government and industry.
- Helps EPA permit officials make decisions about new technologies, it now also
- Guides and assembles research, and
- Distributes information to the states and the biosolids industry.
- microbiology
- virology
- parasitology
- medicine
- veterinary science
- environmental engineering
- wastewater treatment
- industrial hygiene
- sewage sludge regulations
The committee currently consists of 10 members with a well-rounded expertise and diverse point of view. It is a multi-agency group with representatives from US EPA's:
- Office of Research and Development
- Office of Water
- Regional Offices as well as from the
- Center for Disease Control and Prevention.
The pathogen equivalency committee is charged to protect human health. In reviewing an equivalency application, they ensure that new processes employed for sewage sludge treatment are robust and effective in pathogen reduction. In this light, the pathogen equivalency committee reviews and makes recommendations to relevant federal and/or state permitting authorities on the merits of applications proposing new innovative or alternative sewage sludge pathogen reduction processes are equivalent to the processes currently listed in the 40 CFR Part 503, Subpart D, regulation.
For more information on the PEC, refer to Chapter 11 (Role of EPA's Pathogen Equivalency Committee in Providing Guidance Under Part 503) of EPA report Pathogens and Vector Attraction in Sewage Sludge.

What are Processes to Further Reduce Pathogens and Processes to Significantly Reduce Pathogens?
Processes to Further Reduce Pathogens (PRFP) is a treatment process that is able to consistently reduce sewage sludge pathogens (i.e., enteric viruses, viable helminth ova, fecal coliforms, and Salmonella spp.) to below detectable levels at the time the treated sludge is used or disposed (refer to table). PFRP processes and PFRP equivalent processes, when paired with an appropriate vector attraction reduction option, meet the requirements for Class A sewage sludge.
Processes to significantly reduce pathogens (PSRP) is a process that consistently reduces the density of pathogenic bacteria, viruses, and/or parasites (number/gram of biosolids on a dry weight basis) in mixed sludge from a conventional plant by equal to or greater than 1 log, or a factor of 10 (refer to table). PSRP processes and PSRP equivalent processes, when paired with an appropriate vector attraction reduction option, meet the requirements for Class B sewage sludge.
Although PSRP processes are effective in reducing some strains of microorganisms, it is expected that some pathogenic microorganisms will survive PSRP treatment. Therefore, to minimize impact on the environment and to maintain public health, additional restrictions are required for land application of PSRP treated biosolids. Some of these measures include restricting the public’s access to the land application site and preventing crop harvesting for a certain amount of time so that the pathogens naturally attenuate to below the detection limit. More information on site restrictions can be found in Section 5.5 (p 38) of EPA report Pathogens and Vector Attraction in Sewage Sludge.
Table 1 is a comparison of some of the main differences between PFRPs and PSRPs. Additional criteria for demonstrating equivalency to a PFRP or PSRP and generating a quality assurance project plan (QAPP) are located on the equivalency criteria page.
| Process to SIGNIFICANTLY Reduce Pathogens (PSRP) | Process to FURTHER Reduce Pathogens (PFRP) | |
|---|---|---|
| Produce biosolids that meet disinfection requirements for… |
Class B
|
Class A
|
| Expected pathogen/indicator levels: | ||
| - fecal coliform |
< 2 million CFU¹ or MPN² per gram total solids (dry weight)
|
< 1,000 MPN per gram total solids (dry weight)
|
| - Salmonella spp. |
Reduced by a factor of 10
|
< 3 MPN per 4 grams total solids (dry weight)
|
| - enteric viruses |
Reduced by a factor of 10
|
< 1 PFU³ per 4 grams total solids (dry weight)
|
| - viable helminth ova | Not applicable | < 1 viable ova per 4 grams total solids (dry weight) |
| Additional requirements for land application | Vector attraction reduction plus site restrictions after application | Vector attraction reduction |
| Microbiological monitoring requirements to ensure expected pathogen/indicator levels are met | None | Fecal coliform or Salmonella spp. - Average of ≥ 7 samples taken over a two week period and performed anywhere from once per month up to once per year depending on the amount of biosolids produced; or as directed by the permitting authority. |
¹Colony Forming Units (CFU) - A unit of measure received from using the membrane filter method of detection. This method is only approved for use in Class B treated biosolids.
²Most Probable Number (MPN) - A unit of measure received using the multiple tube fermentation method of detection. This method is approved for use with all biosolids and untreated sludge samples.
³Plaque Forming Units (PFU) - A unit of measure received from using a plaque assay method of virus detection.
I have developed or have an idea for a new treatment process and would like to get equivalency. How do I get started?
If you have developed or have an idea for a new sludge disinfection process and are interested in receiving an PEC equivalency recommendation, please first contact your state permitting authority or an EPA Regional Biosolids Coordinator.
Before you make contact, please answer the key questions:
What type of pathogen reduction equivalency are you seeking, PSRP or PFRP? To answer this question you will likely have first performed some limited proof-of-concept studies to establish the pathogen reduction of your treatment process.
Then use the information in the section above to assist you in deciding the type of equivalency you intend to apply for.
Does your process resemble or meet the operating conditions of any current alternatives listed in 40 CFR 503D?

Are you seeking a site-specific or national equivalency? Please refer to the flow diagram (adapted from Figure 11-1 of Environmental Regulations and Technology: Control of Pathogens and Vector Attraction in Sewage Sludge)

How can a process receive a national vs. site-specific equivalency recommendation?
As indicated in the flow diagram above, processes affected by local climatic conditions, or that use materials that may vary significantly from one part of the country to another, are unlikely to be recommended as equivalent on a national level. These processes may only receive a site-specific equivalency recommendation. For a recommendation of national equivalency, the process must consistently produce the required pathogen reductions under the variety of conditions that may be encountered at different locations across the country. A recommendation of national equivalency is usually preferred because it enables the treatment processes to be marketed, sold, or used at different locations in the United States.

Typically, to receive an equivalency recommendation, laboratory work is performed to establish the boundary conditions of all key process variables, and then pilot or full-scale testing is performed to demonstrate successful scale-up. It should be obvious that for a site-specific equivalency this work only needs to be performed on one sewage sludge at one location. For a national equivalency, however, the laboratory work must be repeated with several sewage sludge types. These sewage sludges should include all the different types with which innovative or alternative process might be used and the range of characteristics that the process would be expected to see. In addition, successful scale-up will need to be demonstrated by pilot or full-scale studies at a single location. This, of course, is only the typical manner in which equivalency recommendations are received and there is room for variation from application to application. For instance, if preferred, a mobile pilot-unit could be constructed and used for all testing, eliminating the need for laboratory studies. Note that in cases where pilot testing is used without any full-scale testing, the applicant must ensure that the pilot-scale accurately represents the full-scale (refer to pilot-scale definition).
What is the difference between proof-of-concept, laboratory, pilot, and full scale?
Proof-of-concept typically is used to describe any initial small scale or incomplete investigations into a new treatment process. The purpose of proof-of-concept studies is to determine the feasibility of a new idea or concept. In most cases, data taken before a quality assurance project plan or similar type of document is written will be identified as proof-of-concept and will not be considered by the Pathogen Equivalency Committee as part of an application package.
Laboratory-scale testing is often referred to as bench-scale testing because the scale is such that it can be comfortably carried out on a laboratory bench top. In laboratory-scale testing the equipment employed to carry out the experiments is typically specifically made for laboratory use and is not manufactured in sizes large enough to be included as part of a full-scale process and/or not practical at larger scales. An example of this is the use of a magnetic stirrer to keep sludge samples mixed during treatment. Laboratory-scale testing is simpler and easier to control than the other two scales because of the smaller quantities of sludge used. For this reason it is typically used to develop operating ranges of key process variables before building a pilot or full scale unit.
Pilot-scale testing typically handles volumes larger than the laboratory-scale, but smaller than the full-scale. The defining characteristic of pilot-scale testing is that it is carried out using a pilot-scale unit which is a miniature, but exact replica of the full-scale process. Like a model car to its full-sized counterpart, each component of a pilot-scale unit is exactly the same design as it would be in a “real-life” process. For example, if mixing at the full-scale is to carried out using a recirculation pump which is sized to turn over the entire volume of 10,000 gal tank in 4 hours, the pilot-scale unit would also be mixed by a recirculation pump which would be appropriately sized to turn a smaller volume tank at the same rate. Pilot-scale modeling is often used in engineering disciplines to predict the behavior of a prototype or full-scale system. In order for the model and the prototype to behave in a similar fashion the principles of similitude and dimensional analysis must govern the relationships between physical parameters. True pilot-scale units should be constructed according to these principles. This is especially important when using pilot-scale testing to demonstrate successful scale-up of a process for an equivalency application.
- Equivalency Criteria (refer to Item #3 Demonstration of Successful Scale-up).
Full-scale refers to the scale appropriate to treat sludge from an entire plant. Full-scale testing is not often used because of the large quantities of sludge involved. Full scale testing is only appropriate when an adequate amount of enteric viruses and helminth ova are naturally present in the raw sludge to permit the demonstration of a disinfection process' effectiveness.
What are the benefits of obtaining an equivalency over operating under Alternatives 3 & 4 for Class A, or Alternative 1 for Class B?
An innovative or alternative sludge disinfection process may be marketed, installed, and operated in compliance with the regulations without ever having received PFRP or PSRP equivalency. Alternatives 3 or 4 for Class A and Alternative 1 for Class B offer the flexibility to use processes that do not meet the operating conditions of any of the listed alternatives/processes in 40 CFR 503, Subpart D, by allowing the operators of such processes to show that their sewage sludge products meet the appropriate expected pathogen / indicator levels through comprehensive microbial monitoring.
Class B, Alternative 1 relies on the routine monitoring of only one organism (fecal coliform).
Class A, Alternative 3 relies on microbiological monitoring of three classes of organisms, bacteria (either fecal coliform or Salmonella spp.), viruses (enteric), and parasites (viable helminth ova). The difference between Alternative 3 and 4 is subtle. Alternative 3 is meant to be used in situations where a defined process exists, but its operating conditions do not meet those of any other established process/alternative. Microbial testing must be performed for helminth ova and viruses on the untreated sludge and for bacteria on the treated sludge in Alternative 3. Helminth ova and viruses need only be tested for in the treated sludge when they are detected in the untreated sludge; and only when adequate pathogen reduction is demonstrated can a process be considered Class A.
Class A, Alternative 4 relies on microbiological monitoring of three classes of organisms, bacteria (either fecal coliform or Salmonella spp.), viruses (enteric), and parasites (viable helminth ova). The difference between Alternative 3 and 4 is subtle. Alternative 4 is meant to be used in the rare instance of an orphaned, stockpiled sludge where the method of treatment is unknown. It was intended for one-time testing, not continued use. In such situations, monitoring the untreated sludge is not feasible and all three organisms must be tested for on the treated sludge.
Class A, Alternatives 3 and 4, can be costly because helminth ova and enteric viruses, which are expensive to analyze, must be analyzed at the same frequencies as other pollutants regulated in 40 CFR 503 (e.g. once per month for facilities preparing more than 15,000 dry metric tons of sewage sludge per year). In comparison, if an equivalency determination has been established, only fecal coliform and/or Salmonella spp. must be analyzed to demonstrate Class A, unless special requirements for monitoring are imposed by the permitting authority.
The use of these monitoring alternatives is discouraged except under certain site-specific conditions. Without a defined treatment, the absence of specific organisms cannot be used to infer the absence of other potentially pathogenic organisms in the biosolids. Nor with respect to Class A, Alternative 3 can the absence of these organisms be guaranteed over time without the barrier a treatment technology provides. Thus, it is the Pathogen Equivalency Committee's opinion that the treatment technology alternatives (i.e., Class A Alternatives 1, 2, 5, and 6, and Class B Alternatives 2 and 3) provide better and more consistent protective value from a human health standpoint than microbial testing in the absence of defined treatment. The table summarizes some advantages and disadvantages between choosing the microbiological monitoring route and applying for equivalency.
| Microbiological Monitoring Alternatives (Class A, #3 or #4 and Class B, #1) |
Equivalency Alternatives (Class A, #6 and Class B, #3) |
|
|---|---|---|
| Initial Level of Effort Required to Receive a Permit | Varies; Facility to facility and state to state, depending on the permitting authority | Extensive; Requires the development of a quality assurance project plan and comprehensive testing to establish operating conditions of process parameters and successful scale-up |
| Long Term Level of Effort Required to Satisfy Permit Conditions | High; Requires continued microbiological testing at a level and/or frequency above that of all other sludge disinfection alternatives | Low - Medium; Requires monitoring of process parameters and microorganism (Class A only) at a level and frequency equal to that of all other alternatives |
| Level of Confidence in Product Produced | Varies; Depending on the consistency of the process and the product and the representativeness of the sampling [Remember that the use of helminth and enteric viruses does not verify product quality and can only verify treatment efficacy if found in the raw sludge in sufficient quantities.] | Very High; A new process is rigorously challenged during the equivalency application process |
| Ease of Process Transferability and Marketing | Varies; Permits are evaluated and granted on a case-by-case basis and marketing is hindered by the need for a continued high level of microbiological testing | High; An equivalent process, even a site-specific one, carries a level of prestige and reliability that makes the process more marketable and more easily accepted elsewhere |
What are fecal coliform, Salmonella spp., enteric viruses, and helminth ova and why were they chosen to demonstrate equivalency?
The cast of characters involved in the demonstration of equivalency is taken directly from the 40 CFR 503, Subpart D, regulations for Class A and Class B disinfection processes. Each microorganism has its own unique characteristics.
Fecal Coliform

A-1 broth. Gas production from fecal coliform
lactose fermentation in the positive tube on left and negative tube on right.
Fecal coliforms are a group of bacteria which, as their name suggests, are largely associated with fecal contamination. Defined by their method of detection, fecal coliform include any bacteria that ferment lactose to produce acid and gas at a temperature of 44.5° C within 24 hours. Most fecal coliform are not pathogenic, but beneficial to their host. They are one of many groups of organisms that live in the intestinal tract of animals, including humans, where they aid in the digestion of food and recovery of nutrients. A percentage of these naturally occurring bacteria are continually lost through fecal wastes which balances the population growth within the intestines.
The fecal coliform group is largely made up of two genera of bacteria; Escherichia and Klebsiella. Not all fecal coliform are associated with fecal contamination. Some species of Klebsiella, for instance, are commonly found in vegetation (e.g., wood). Within the fecal coliform group there are numerous strains of Escherichia coli, a few of these are known to be pathogenic. However, the fraction of pathogenic strains of E. coli in wastewater typically are so low that it is difficult (and in most cases impossible) to detect them. Fecal coliform are widely used as an indicator of pollution because they are directly proportional to fecal wastes, present in high numbers, and easier to quantify than pathogens. Also, their low pathogenicity makes the fecal coliform group safer to analyze as opposed to measuring pathogens directly. Fecal coliform are used to demonstrate sewage sludge safety and process equivalency for the same reasons.
Salmonella spp.
Salmonella is a genus consisting of a number of disease causing bacteria species. The measurement methods used in sewage sludge analysis do not differentiate between species, so Salmonella is often seen followed by “spp.” which is short for species (plural) and used when referring to the entire genus. (Aside - “sp.” is short for singular species, used when referring to only one species of Salmonella.) Salmonella spp. are rod-shaped, Gram-negative bacteria, the majority of which cause illness. The most infamous illness caused by a Salmonella sp. is typhoid fever. Although typhoid fever is no longer common in the United States, it still poses a serious threat in third-world countries. Typhoid fever can cause symptoms such as nausea, vomiting, fever, and death.
The Salmonella sp. S. enteritidis is currently the single most common cause of food poisoning in the United States. The symptoms of S. enteritidis are non-fatal gastroenteritis. S. enteritidis is generally associated with improper handling or undercooking of poultry and eggs. Salmonella spp. were chosen as an indicator of sewage sludge safety mainly because of interference of non-fecal associated fecal coliform stemming from the use of wood chips and sawdust as bulking materials, especially in composting practices. Since S. enteritidis is so widespread, sufficient numbers of Salmonella spp. typically exist in untreated sewage sludge. Thus, if Salmonella spp. are at or below the detection limit (3 MPN Salmonella / 4 grams total solids (dry weight)) in the treated sludge, one usually can be assured that effective disinfection has occurred.
Enteric Viruses

Viruses, in general, are particles containing genetic information which cannot replicate without a living host. As the name implies, enteric viruses are a subset of these particles that are associated with fecal contamination (enteric means pertaining to the intestines). These viruses must be hardy enough to survive the harsh environment of stomach acids and bile salts. Once in the gut they attach to the mucous coating and invade the host’s cells to multiply in numbers.
Enteric viruses include: rotaviruses, astroviruses, caliciviruses, picornaviruses, adenoviruses, parvoviruses, and reoviruses. Most of these viruses cause viral gastroenteritis. For example, rotaviruses are the leading cause of childhood gastroenteritis world-wide. Left untreated it can lead to death, primarily due to severe dehydration. The picornavirus family is particularly significant. It includes more well-known viruses such as the poliovirus, coxsackievirus, and the hepatitis viruses. Most picornavirus are associated with diseases other than gastroenteritis, such as, Polio, viral hepatitis, myalgia, pancreatitis, diabetes, myocarditis, hand-foot-and-mouth disease, and conjunctivitis.
Enteric viruses were selected as an indicator of sewage sludge treatment effectiveness for two primary reasons. First, they are shed in large numbers by infected individuals and, therefore, likely to be present in untreated sewage sludge. Second, they are inherently resistant to environmental stresses, including heat and low pH. Thus, if conditions are effective for the disinfection of enteric viruses one can be reasonably assured that they are effective for most other viruses and bacteria.
Viable Helminth Ova

Helminths are parasitic worms. There are three main classes of helminths that are important from a human health standpoint: nematodes (roundworms), cestodes (tapeworms), and trematodes (flukes). Helminths typically enter the human body through the mouth and lodge in the intestines where they hatch, grow into adult worms, and begin producing eggs or ova. The ova are then passed out of the body with feces. Some helminths can infect areas of the body other than the intestines. For example, the adult roundworm Trichina spiralis can migrate into muscle tissue, including the heart, and brain tissue causing a fatal disease called trichinosis.

Ascaris lumbricoides ova are often specifically referred to when testing sewage sludge. This parasite is the largest intestinal roundworm found in humans. The females typically reach 20 to 35 cm in length. Ascaris ova are the organism of choice for evaluating treatment effectiveness because they have thick shells which are very resistant to stressors, especially chemical stressors, commonly used in sludge disinfection methods. At one time helminth ova were commonly found in relatively large numbers in sewage sludge in the United States. Due to cleaner water supplies and better personal hygiene practices, helminth infections have been steadily decreasing in the United States. Thus, levels of helminth ova in sewage sludge have also been decreasing. Thus, the absence of helminth ova in treated sludge is no longer an acceptable indicator of adequate pathogen reduction since there is a high likelihood that a measurable level of helminth ova did not exist in the untreated sludge. However, due to its high resistance to treatment conditions, it is still useful in evaluating treatment effectiveness in process equivalency evaluations.
